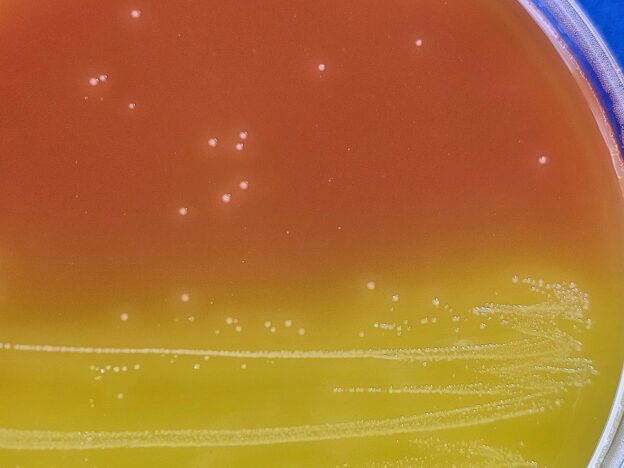

ISO 15213-3:2024 Clostridium perfringens en alimentos
Medios RPM y LENA
Nace una nueva Norma ISO para la búsqueda de Clostridium perfringens en alimentos, que recopila varios medios antiguos (FTM, Lactosa-gelatina-rojo fenol, movilidad, Crosley Milk Medium…) formulados en dos nuevos medios, ya disponibles en MICROKIT:
1-PERFRINGENS RAPID MEDIUM BASE (RPM) DMT293
https://www.microkit.es/fichas/C-PERFRINGENS-RAPID-MEDIUM-BASE-RPM.pdf
Aislamiento y cultivo de Clostridium perfringens en alimentos según ISO 15213-3:2024
COMPOSICION
Yeast Extract 11,0 g
Enzimatic Digest of casein 15,0 g
Enzymatic digest of animal tissue 10,0 g
Glucose/Dextrose 10,5 g
Sodium thiogycollate C2H3NaO2S 0,5 g
Sodium chloride NaCl 5,5 g
L-cystine C6H12N2O4S2 0,5 g
Resazurin Sodium salt C12H6NNaO4 0,001 g
Dipotassium hydrigenophosphate HK2PO4 10,0 g
Iron (II) Sulphate heptahydrate (H14FeO11S) 1,0 g
Gelatin (AlH3KO8S2) 120,0 g
Agar-agar 1,5 g
(Fórmula en g/L)
Ajustar a pH final tras autoclavado: 6,6 ± 0,2
PREPARACION
1-Disolver 185,5 g de medio en 1 litro de agua bidestilada. Calentar hasta ebullición, agitando para su total homogeneización. Dispensar en tubos o frascos herméticos y esterilizar en autoclave a 121ºC durante 5 min. No sobrecalentar. El color final del medio es crema-ámbar. Se puede hacer stock de este RPM base esterilizado, manteniendo hasta 4 semanas a 5ºC.
2-Llevar hasta 47-50 ºC, 300 mL de RPM base y añadir 6 mL de una solución de Neomycina sulfato (0,75 g) y Polymyxina B sulfato (0,125 g) SMT014 esterilizada por filtración (por 0,2 µ) en 100 mL de agua destilada estéril. Esta solución antibiótica se puede mantener a 5ºC durante 4 semanas en tubos o frascos herméticos.
3-Añadir a los dos anteriores 300 mL de leche en polvo entera (DMT294), llevada a 44-47ºC (100 g en 1000 mL de agua destilada, que haya sido esterilizada por autoclavado de 5 minutos a 121ºC). Se puede hacer stock de esta leche esterilizada, manteniendo hasta 4 semanas a 5ºC en recipientes herméticos.
4- Agitar hasta que los 3 ingredientes queden homogéneos. Dispensar 9 mL en tubos estériles o bien 90 mL en frascos estériles
USO EXCLUSIVO EN LABORATORIO. MANTENGA EL BOTE BIEN CERRADO, EN LUGAR SECO, FRESCO Y OSCURO. AGITAR ANTES DE USAR PARA ASEGURAR LA HOMOGENEIZACIÓN DE LOS eventuales gradientes de densidad de los COMPONENTES.
PRESENTACIÓN:
-Medio deshidratado RPM BASE, botes 500 g, CÓDIGO: DMT293
-Neomycina + Polimixina NO estéril en viales de 0,75 + 0,125 g, caja 40 viales CÓDIGO: SMT014
-Agua destilada estéril en Frascos de 100 mL CÓDIGO: RPL001
-Filtros estériles de carcasa para jeringa (lúer), 0,2 µm y 30 mm de diámetro, CÓDIGO: VHU237
-Jeringas estériles 50 mL para los filtros VHU237, CÓDIGO: VPL090
-Leche entera en polvo, exenta de antibióticos y de esporas CÓDIGO: DMT294
https://www.microkit.es/fichas/WHOLE%20MILK.pdf
CONTROL DE CALIDAD
Realizado en nuestro laboratorio; es prudente repetirlo en su laboratorio siempre que varíen las condiciones (más de 3 meses sin usar, tras desinfectar laboratorio, tras conservar a alta Tª, cuando adquiere aspectos extraños aunque no haya llegado la fecha de caducidad teórica de la etiqueta,…)
DESHIDRATADO: Polvo de color crema PREPARADO: Estéril, color crema-ámbar. Enrojece si se oxigena
CONTROL DE CRECIMIENTO CUANTITATIVO 18 horas a 46ºC aproximadamente:
Clostridium perfringens WDCM00007 Crecimiento correcto
MODO DE EMPLEO E INTERPRETACIÓN DE RESULTADOS
Seguir las directrices de la Norma ISO 15213-3:2024
Emplear también el Agar LENA (Lactose Egg-Yolk Neomycin Agar): Ver DMT295
2-PERFRINGENS LACTOSE AGAR BASE (LENA) DMT295
https://www.microkit.es/fichas/C-PERFRINGENS-LACTOSE-AGAR-BASE-LENA.pdf
Aislamiento y cultivo de Clostridium perfringens en alimentos según ISO 15213-3:2024
COMPOSICION
Enzimatic digest of casein 10,0 g
Meat extract 10,0 g
Sodium chloride NaCl 5,0 g
Lactose C12H24O12 10,0 g
Phenol Red C19H14O5S 0,1 g
Agar-agar 15 g
(Fórmula en g/L)
Ajustar a pH final tras autoclavado: 7,3 ± 0,2
PREPARACION
1-Disolver 50,1 g de medio en 1 litro de agua bidestilada. Calentar hasta ebullición, agitando para su total homogeneización. Dispensar en tubos o frascos herméticos y esterilizar en autoclave a 121ºC durante 15 min. No sobrecalentar. El color final del medio es naranja. Se puede hacer stock de este LENA base esterilizado, manteniendo hasta 4 semanas a 5ºC.
2-Llevar hasta 44-47 ºC, 100 mL de LENA base y añadir 1 mL de una solución de Neomycina sulfato (0,25 g) SMT015 esterilizada por filtración (por 0,2 µ) en 10 mL de agua destilada estéril. Esta solución antibiótica se puede mantener a 5ºC durante 4 semanas en tubos o frascos herméticos.
3-Añadir a los dos anteriores 5 mL de emulsión estéril de yema de huevo SBH010. Agitar hasta que los 3 ingredientes queden homogéneos
4-Dispensar en placas Petri estériles. Las placas así preparadas se pueden mantener en tuppers de cierre hermético (para que no pierdan humedad) durante 4 semanas a 5ºC.
USO EXCLUSIVO EN LABORATORIO. MANTENGA EL BOTE BIEN CERRADO, EN LUGAR SECO, FRESCO Y OSCURO. AGITAR ANTES DE USAR PARA ASEGURAR LA HOMOGENEIZACIÓN DE LOS eventuales gradientes de densidad de los COMPONENTES.
PRESENTACIÓN
-Medio deshidratado LENA BASE, botes 500 g, CÓDIGO: DMT295
-Neomycina NO estéril en viales de 0,25 g, caja 40 viales CÓDIGO: SMT015
-Agua destilada estéril en Tubos de 10 mL CÓDIGO: TPL001+
-Filtros estériles de carcasa para jeringa (lúer), 0,2 µm y 30 mm de diámetro, CÓDIGO: VHU237
-Jeringas estériles 20 mL para los filtros VHU237, CÓDIGO: VPL089
-Emulsión de yema de huevo estéril CÓDIGO SBH010
CONTROL DE CALIDAD
Realizado en nuestro laboratorio; es prudente repetirlo en su laboratorio siempre que varíen las condiciones (más de 3 meses sin usar, tras desinfectar laboratorio, tras conservar a alta Tª, cuando adquiere aspectos extraños aunque no haya llegado la fecha de caducidad teórica de la etiqueta,…)
DESHIDRATADO: Polvo de color crema PREPARADO: Estéril, color crema-ámbar. Enrojece si se oxigena
CONTROL DE CRECIMIENTO CUANTITATIVO 24 horas a 46ºC aproximadamente:
Clostridium perfringens WDCM00007 Colonias con halo amarillo precipitado
E.coli WDCM00012 Completamente inhibido
Bacillus subtilis WDCM00003 Colonias amarillas sin halo de precipitación
MODO DE EMPLEO E INTERPRETACIÓN DE RESULTADOS
Seguir las directrices de la Norma ISO 15213-3:2024
Emplear también el Rapid perfringens Medium BASE (RPM): Ver DMT293
Tambien hay que emplear otros medios clásicos (TSC Agar, Columbia Blood Agar, SIM Agar) y reactivos (Indol Kovacs, fosfatasa ácida -cancerígena- la cual imaginamos permitirán sustituir por MUP como en la búsqueda de C.perfringens en aguas por demostrarse como método equivalente)
https://www.microkit.es/fichas/TSC-AGAR-MUP.pdf
https://www.microkit.es/fichas/COLUMBIA-AGAR.pdf
https://www.microkit.es/fichas/SIM-MEDIUM.pdf
Haga sus consultas de RPM y LENA y demás temas mencionados de Clostridium perfringens en: microkit@microkit.es
Haga sus pedidos de RPM y LENA y demás temas mencionados de Clostridium perfringens en pedidos@microkit.es